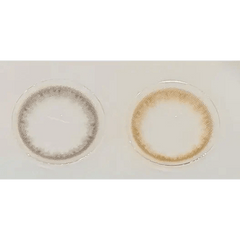
Olens Spring Rain Gray

★ From Korea – Welcome to KPOP2! We offer 1,100+ Korean colored contacts shipped worldwide with tracking to 185 countries.
★ Currently, only expedited shipping is available in the US. Standard shipping is temporarily suspended.
See detailed shipping info
The Olens Spring Rain Gray contact lenses are designed to add a gentle gray touch to your eyes, giving you a refreshing and natural look. Made by OLENS, South Korea’s leading lens brand, these monthly disposable contacts combine style, comfort, and safety. Perfect for both everyday wear and special occasions, Spring Rain Gray enhances your eyes without being too bold or artificial.
With 38% water content, these lenses keep your eyes hydrated and reduce dryness during long wear.
Available in plano (0.00) for cosmetic use and up to -8.00 for those with nearsightedness, they meet both fashion and vision needs.
As monthly disposables, these lenses offer a great balance between affordability and hygiene.
Crafted from HEMA (Hydroxyethyl Methacrylate), these lenses are lightweight, breathable, and gentle on the eyes.
The Spring Rain Gray shade provides a subtle, elegant gray that looks natural even on dark eyes, making them versatile for daily wear.
At 13.1mm, the graphic diameter offers a natural enlargement effect without overpowering your natural iris.
With a 14.0mm diameter, the lenses strike a balance between comfort and enhancement.
The 8.6mm base curve ensures a comfortable and stable fit for most users.
Thanks to its HEMA material and water content, Spring Rain Gray maintains breathability and reduces eye strain.
These lenses are designed for all-day wear, making them practical for work, school, or social outings.
Each lens is packaged in a sealed bottle, ensuring hygiene and sterility until opened.
Each bottle contains 1 lens, so you’ll need two bottles for a complete pair.
These lenses add a subtle sparkle to your eyes, enhancing them without looking overly dramatic.
Whether for casual days, professional settings, or special events, Spring Rain Gray offers a versatile, natural look.
As a leader in K-beauty contact lenses, OLENS ensures both safety and style with every product.
"From Korea to You" - Welcome to KPOP2! We safely and quickly ship over 1,100 beautiful Korean colored circle lenses worldwide.
We offer Standard and Express shipping to meet your needs.
For more details, please visit our Shipping Service page and Exchange & Return Policy page.
At KPOP2, your well-being is our top priority. We’re dedicated to ethical, responsible practices, offering only authentic and safe circle lenses. Our trusted manufacturers in South Korea meet international standards, certified by respected organizations like the U.S. FDA, ISO, and CE.
We guarantee that every KPOP2 product is 100% genuine. If you ever have concerns, we offer a hassle-free refund—your trust in our products means everything to us.
All our products are manufactured and shipped directly from Korea. Despite being near regions known for counterfeit items, we do not source contact lenses from these areas, ensuring only the highest quality.
At KPOP2, we are committed to delivering safe, authentic, and high-quality lenses that enhance your look while protecting your eye health. Thank you for trusting us to be part of your beauty journey!
The gray color of these lenses is just right. They’re comfortable and enhance my eyes beautifully.
The gray color of these lenses is just right. They’re comfortable and enhance my eyes beautifully.
Thanks for subscribing!
This email has been registered!